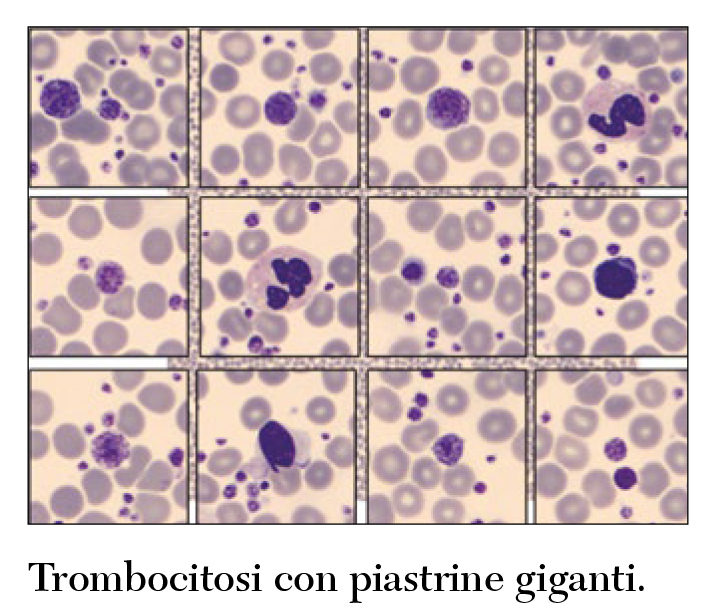
Fig 5 Cesari
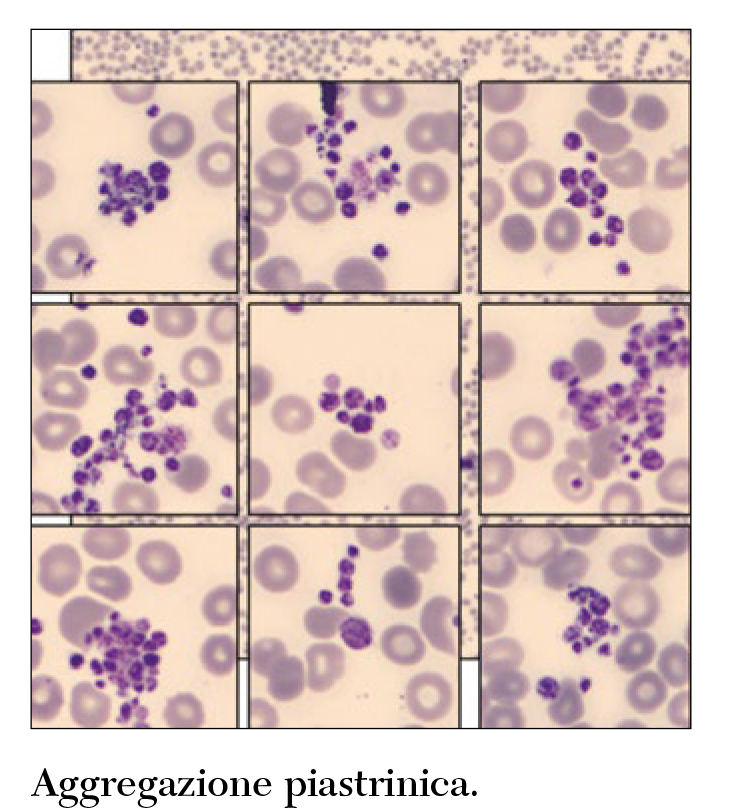
Fig 6 Cesari
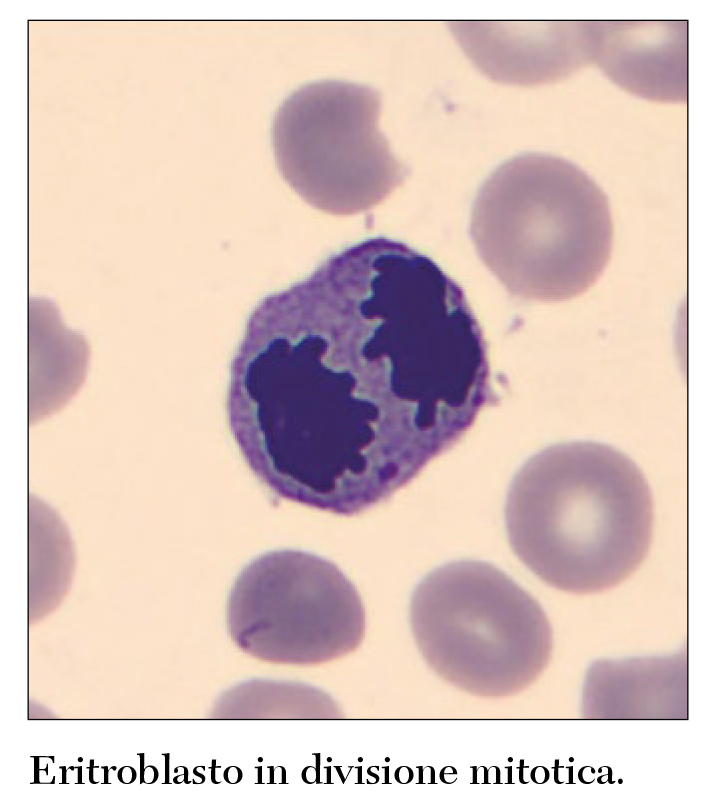
Fig 10 Cesari
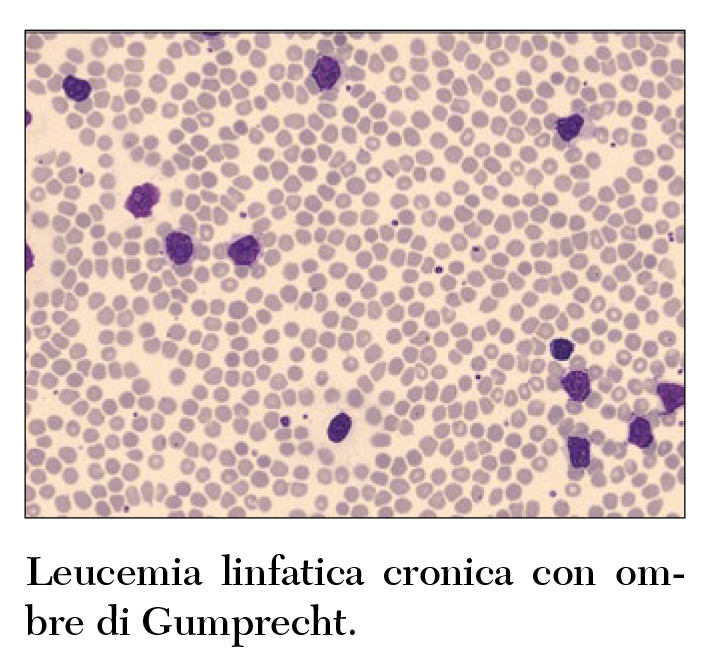
Fig 3 Cesari
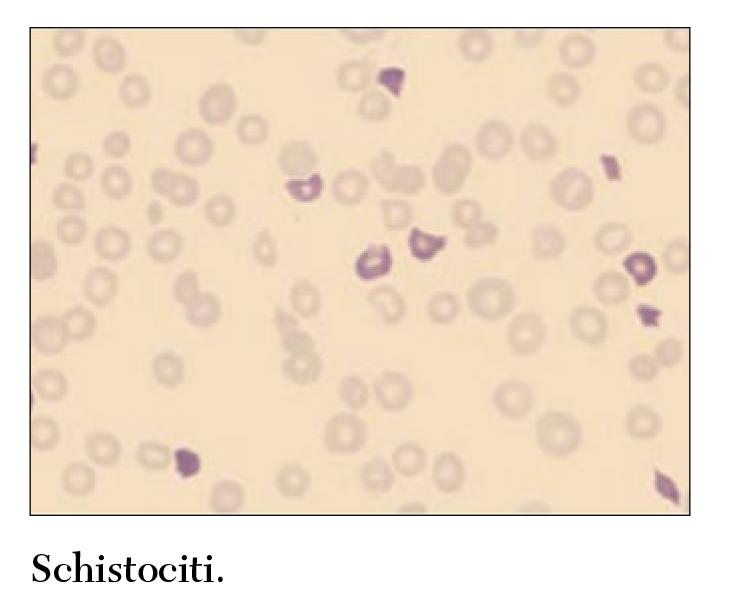
Fig 7 Cesari
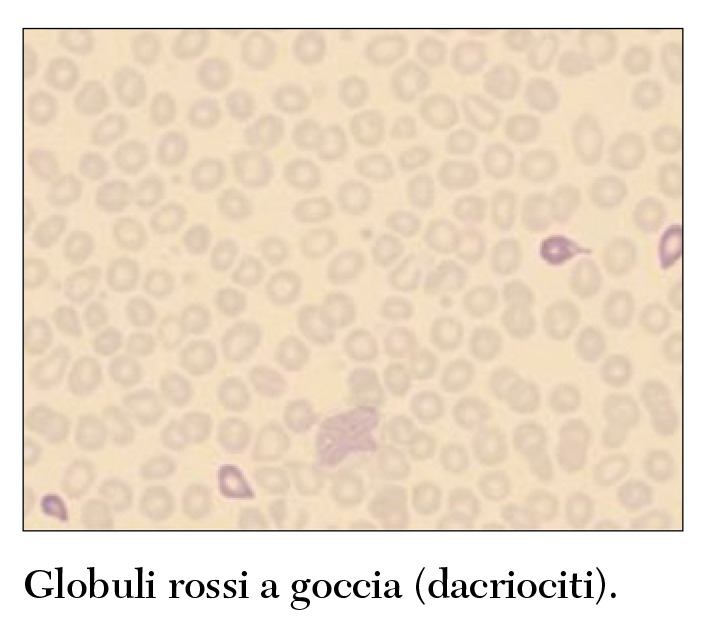
Fig 8 Cesari
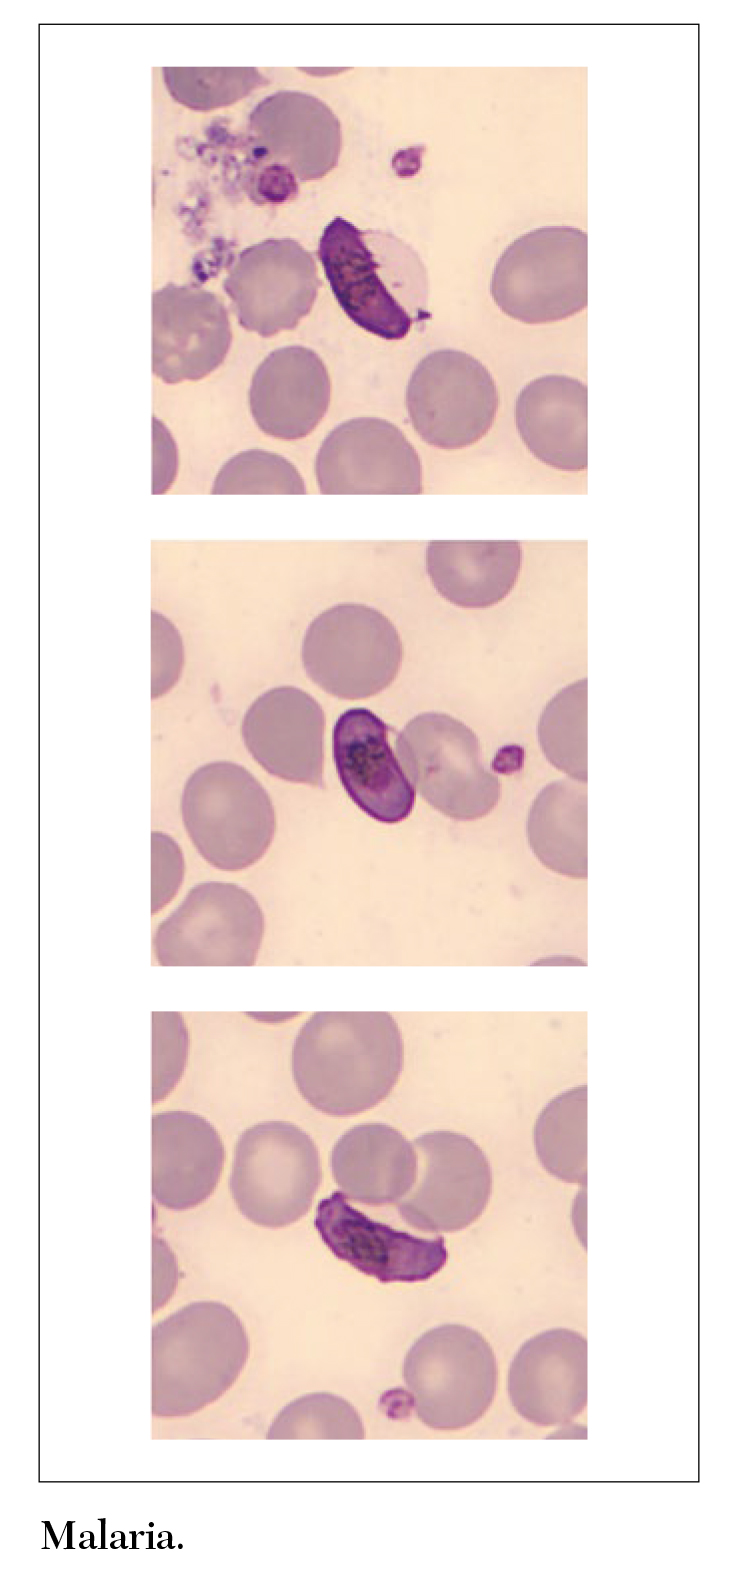
Fig 11 Cesari

La tecnologia attuale riveste un ruolo di grande importanza nella diagnostica ematologica di laboratorio. Ancora oggi non si può tuttavia prescindere dall’operato di professionisti accuratamente formati.
Parole chiave:
esame morfologico, striscio di sangue periferico, analizzatore di immagini
L’esame morfologico cellulare dello striscio di sangue periferico rappresenta, ancora oggi, un’indagine diagnostica di fondamentale importanza in quanto:
• può permettere una diagnosi definitiva;
• è uno strumento importante per le diagnosi differenziale e per l’indicazione a eseguire ulteriori test;
• ha un ruolo cruciale nell’identificazione e nella caratterizzazione delle neoplasie ematologiche
Nonostante gli enormi avanzamenti tecnologici delle metodiche citofluorimetriche e di genetica molecolare avvenute negli ultimi anni, tale importanza diagnostica è ribadita anche nell’ultima edizione della classificazione WHO delle patologie ematologiche. La morfologia è infatti lo specchio della funzionalità cellulare, evidenziandone maturità, immaturità, asincronia maturativa, reazione agli stimoli, attivazione, morte, e l’analisi morfologica si configura come il processo ricognitivo interpretativo che consente di prendere decisioni di differenziazione e di catalogazione delle cellule e, quindi, decisioni cliniche.
Come evidenziato nel fondamentale lavoro di Barbara Bain, sono numerose le indicazioni cliniche che richiedono l’esame morfologico dello striscio di sangue periferico (Tabella I) così come sono numerose le osservazioni fortuite che hanno poi un’importanza diagnostica (Tabella II).
L’impressionante miglioramento delle tecniche di imaging digitale degli ultimi anni ha aperto la strada all’uso dell’analizzatore di immagini in sostituzione o complementare al classico microscopio ottico.
Tramite questo strumento, le immagini microscopiche delle cellule ematologiche sono fotografate utilizzando camere digitali a elevata risoluzione in grado di produrre immagini dettagliate di porzioni citologiche, che possono poi essere visionate utilizzando monitor a elevato ingrandimento. Il mercato offre diversi analizzatori di immagini ematologici approvati dall’FDA; dal 2011 nel Laboratorio Generale dell’AOU Careggi è in uso il DM-96 CellaVision, da pochi mesi sostituito dalla sua evoluzione, il DI-60 CellaVision.
In un’interessante review sull’argomento, Kratz e collaboratori hanno messo ben in evidenza vantaggi e svantaggi di questo strumento.
L’analizzatore di immagini presenta vantaggi analitici, tra cui la standardizzazione della zona di analisi, il conteggio rapido e meno faticoso, la pre-classificazione dei globuli bianchi con possibilità di confronto con immagini di riferimento, la maggiore oggettività morfologica e la maggiore sensibilità nel riconoscimento delle cellule rare. In secondo luogo, ci sono innegabili vantaggi legati alla connettività: operatori diversi che si trovano a distanza possono visualizzare le stesse immagini, le immagini non sono soggette a deterioramento e sono facilmente archiviabili, si ha la totale tracciabilità del dato ematologico morfologico.


Importante anche l’impatto sull’attività didattico-formativa: tramite l’uso di immagini digitali si può armonizzare la professionalità degli specialisti, facilitarne l’addestramento e la formazione continua (E-learning), viene stimolata la ricerca scientifica mediante la creazione di database di immagini per studi mono o multicentrici, si migliora la qualità interna con la realizzazione di programmi di Verifica Esterna di Qualità. Ultimo impatto, non meno importante, è quello inerente l’accuratezza e la tempestività diagnostica con confronti su casistica clinico-patologica complessa e consulti a distanza (la cosiddetta second opinion). Ovviamente la visualizzazione ottimale richiede attrezzature di alta qualità, hardware e software standardizzati, utilizzatori con esperienza e competenza nella lettura dei vetrini al microscopio e confidenza con le prestazioni strumentali.
Nella stessa review sono stati messi in evidenza anche i punti deboli di tale strumentazione, in primis i possibili errori nella preclassificazione delle cellule, soprattutto di quelle patologiche quali blasti, granulociti immaturi, cellule displastiche, schistociti, eventuale presenza di parassiti intra-cellulari ecc.
Da qui risulta indispensabile che gli operatori che si approcciano alla morfologia digitalizzata siano formati adeguatamente al riconoscimento di tali cellule e soprattutto mantengano tale formazione nel tempo, come miglioramento continuo della professionalità acquisita.
L’introduzione dell’analizzatore di immagini nell’ematologia di laboratorio ha radicalmente modificato il flusso del lavoro, soprattutto se l’analizzatore risulta incorporato nei sistemi di total lab automation come nel Laboratorio Generale dell’AOU Careggi.
La decisione del professionista di laboratorio di inviare o meno il campione alla revisione microscopica viene presa in seguito a precise regole di validazione preimpostate sui middleware di ematologia a seconda delle caratteristiche del laboratorio, della casistica che vi affluisce e delle linee guida adottate.
Gli strisci di sangue periferico vengono effettuati automaticamente e in maniera standardizzata da appositi strumenti per striscio e colorazione regolati in base alla consistenza del campione.
Gli strisci, dopo colorazione, vengono inviati all’analizzatore di immagini, dove la camera digitale genera immagini ad alta risoluzione dei globuli bianchi, dei globuli rossi e delle piastrine. Tramite una rete neurale che considera un enorme numero di caratteristiche citoplasmatiche e nucleari quali le dimensioni, la forma ecc., il software incorporato al sistema è in grado di distinguere le cellule e di operare una preclassificazione nelle varie sottopopolazioni leucocitarie.
Il numero delle cellule contate può essere definito dal professionista ma le linee guida internazionali raccomandano la lettura di almeno 200 cellule per vetrino.

I risultati dell’analisi vengono presentati sia in numero assoluto che in percentuale e devono essere giudicati da un professionista di laboratorio esperto per la conferma o la modifica della pre-classificazione. I risultati validati dall’esperto vengono poi inviati al sistema informatico di laboratorio e da qui alla cartella clinica informatizzata.
La corretta preclusterizzazione di specifici subset patologici è stata recentemente implementata attraverso lo sviluppo di algoritmi in grado di aiutare il professionista di laboratorio nella corretta discriminazione fra linfociti normali e patologici.
Passi in avanti sono stati fatti anche nel campo della morfologia digitale dei globuli rossi. Gli analizzatori di immagini di ultima generazione sono in grado di generare da 2.000 a 4.000 singole immagini di globuli rossi. Le cellule sono poi preclassificate sulla base di numerosi algoritmi mofologici in varie sottopopolazioni (schistociti, target cells, dacriociti ecc.) che come sempre richiedono la supervisione del professionista esperto per il giudizio definitivo.
Ancora più recentemente sono stati sviluppati software per l’identificazione nelle immagini digitali delle inclusioni cellulari. Tuttavia, queste applicazioni non sono ancora FDA-approved e necessitano di ulteriori miglioramenti prima di poter essere utilizzate nella routine diagnostica.
Ultimo ma non meno importante è l’utilizzo dell’analizzatore di immagini nella valutazione morfologica degli elementi cellulari presenti nel liquor e nei liquidi cavitari (liquido pleurico, ascitico, pericardico ecc). Con i sistemi attualmente in uso, la preclassificazione delle cellule è buona nella maggior parte dei liquidi cavitari ma a tutt’oggi non è possibile identificare le cellule mesoteliali o le cellule neoplastiche.
In conclusione, nel contesto di una struttura assistenziale complessa e a elevata intensità di cura come l’AOU Careggi dove mediamente, nell’ambito della diagnostica ematologica del Laboratorio Generale, si revisionano microscopicamente circa 6.000 strisci di sangue venoso periferico all’anno, l’adozione di un sistema come l’analizzatore di immagini ha sicuramente portato a una maggiore velocità di revisione, di sensibilità e di specificità nel riconoscimento e nella classifica-zione delle malattie ematologiche, ma non si può ancora prescindere dalla presenza di professionisti formati e competenti che risultano fondamentali nella qualità del referto diagnostico.
cesarif@aou-careggi.toscana.it



